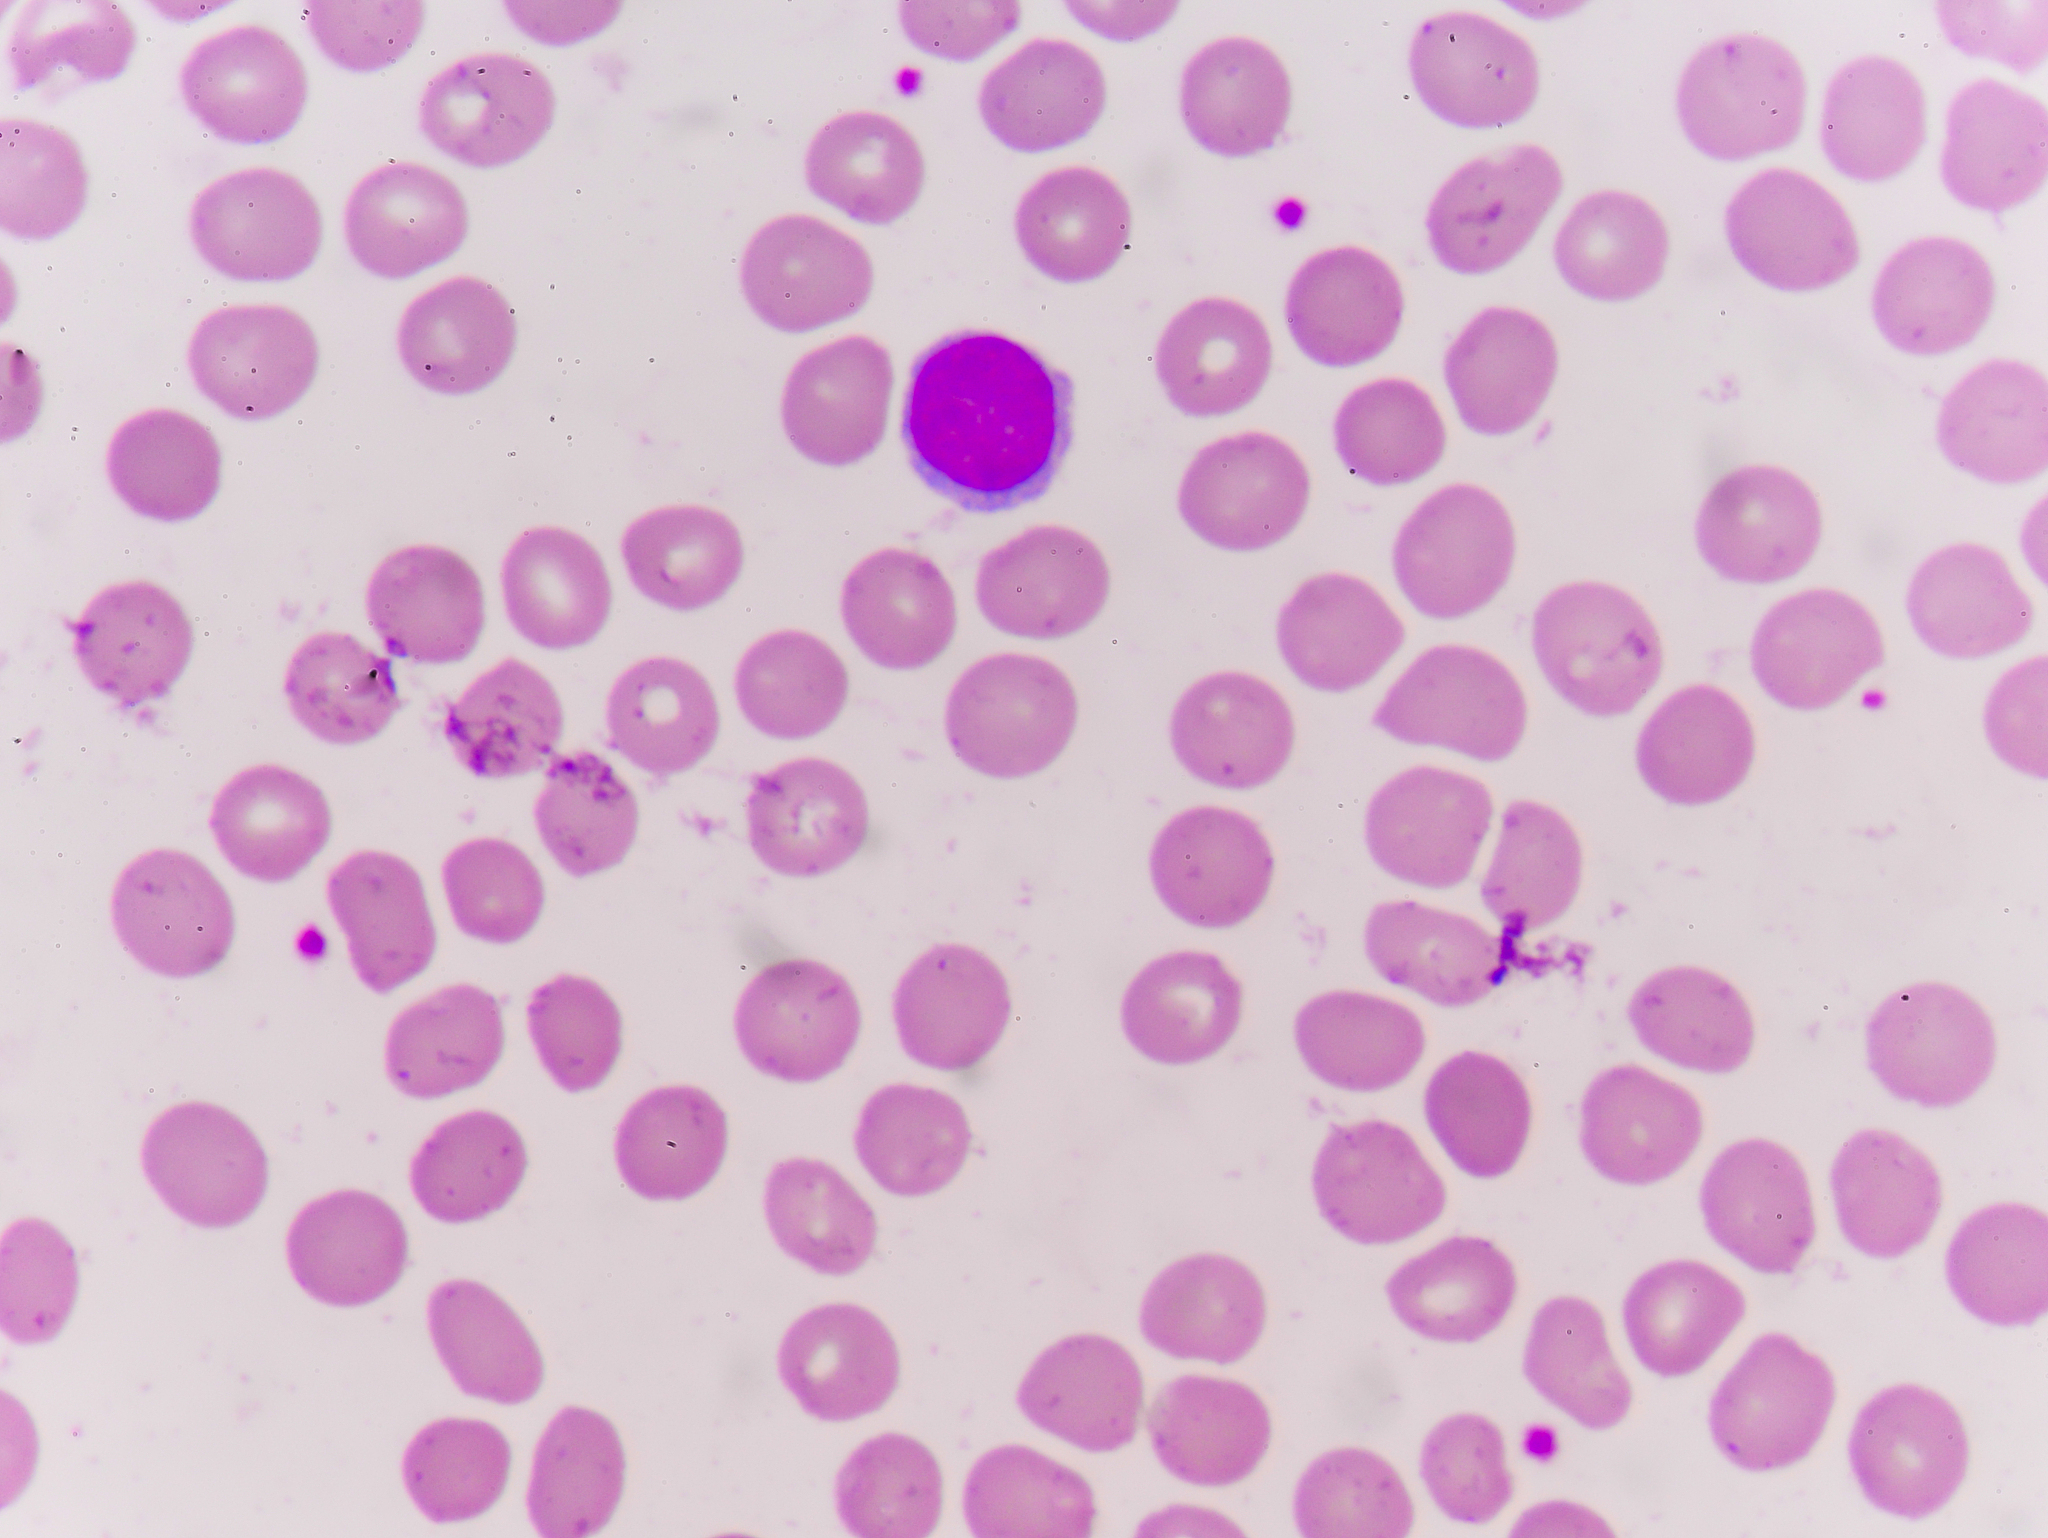
活性氧对于血管内皮有哪些影响

活性氧对于血管内皮有哪些影响
活性氧对血管内皮具有不良影响,主要表现为以下几个方面:
-
损伤血管壁:活性氧会破坏血管内皮细胞膜的完整性,使得细胞膜通透性增加,导致血管内皮细胞损伤。
-
促进氧化应激:活性氧的过度生成会导致氧化应激反应,使得细胞内产生过多的自由基,进而释放一系列促炎因子和细胞因子,加重血管内皮细胞炎症反应。
-
促进血管炎症:活性氧会激活血管内皮细胞的炎症反应,使得内皮细胞表面粘附分子的表达增加,导致白细胞黏附在内皮细胞上,从而引发血管炎症。
-
损伤血管弹性:活性氧会破坏血管内皮细胞的胶原纤维和弹性纤维,使得血管弹性降低,增加血管硬化和动脉粥样硬化的风险。
因此,活性氧对于血管内皮具有显著的不良影响,容易导致血管损伤、炎症和硬化等疾病。
原文地址: https://www.cveoy.top/t/topic/egUj 著作权归作者所有。请勿转载和采集!